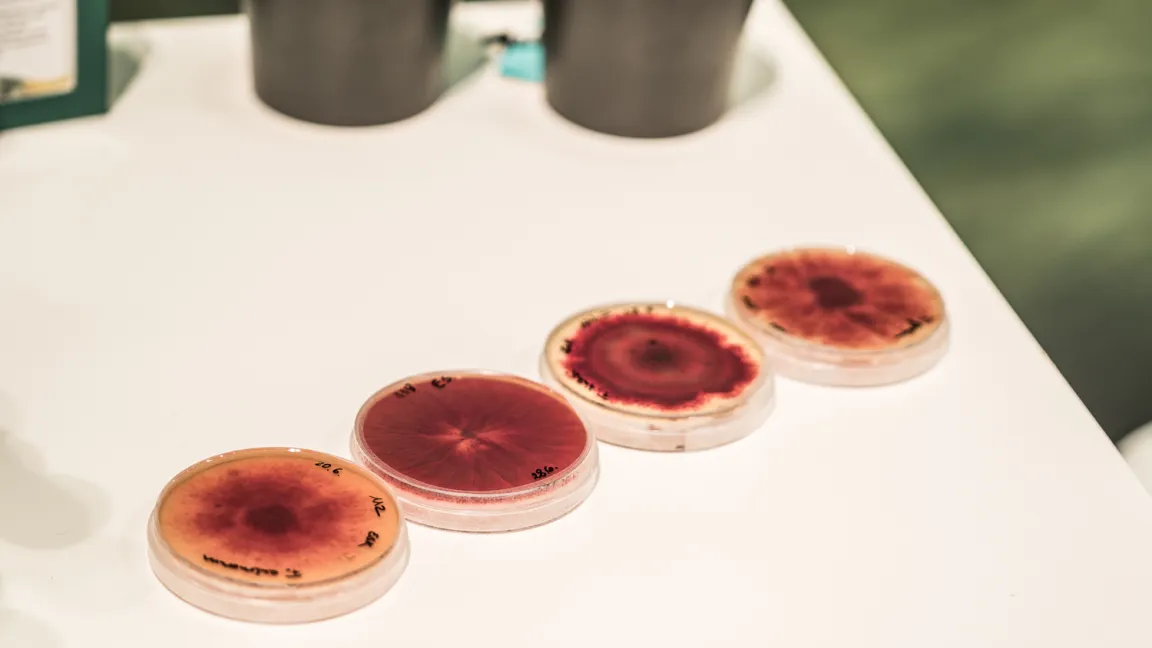

IVA auf der Internationalen Grünen Woche 2018 in Berlin
83. Auflage der weltgrößten Verbraucherschau für Landwirtschaft, Ernährung und Gartenbau am Sonntag in Berlin zu Ende gegangen / erneut knapp 400 000 Besucher
Die Internationale Grüne Woche 2018 in Berlin (19. bis 28. Januar) unterstrich erneut ihren Stellenwert als Leitmesse und Dialogplattform für das gesamte Agribusiness. Die 10-tägige, besucherstärkste Messe Berlins verzeichnete eine erfolgreiche 83. Ausgabe seit 1926 mit einem Zulauf von 400 000 Besuchern, die in die Messeshallen unter dem Funkturm strömten, darunter über 90 000 Fachbesucher.1660 Aussteller aus 66 Ländern (2017: 1650/66 Länder) zeigten einen umfassenden Überblick über den Weltmarkt der Ernährungsindustrie sowie eine Leistungsschau der Landwirtschaft und des Gartenbaus.
Der Industrieverband Agrar e. V. (IVA) lud wieder zum Dialog auf die Messe. Am "Treffpunkt Pflanzenschutz und Pflanzenernährung" im ErlebnisBauernhof in Halle 3.2 stellten sich Experten auch kritischen Fragen zur Agrarchemie und dem Austausch mit den Messebesuchern, etwa zum Einfluss der Landwirtschaft auf die Artenvielfalt, zur Biodiversität oder zum Gewässerschutz. Dabei ging es auch darum, den Besuchern mal eine andere Perspektive auf die Themen Pflanzenschutz und Düngung zu eröffnen.
Die „Pflanzendoktoren“ der Deutschen Phytomedizinischen Gesellschaft (DPG) waren auch 2018 wieder am IVA-Stand dabei. Sie gaben einen Einblick in ihre Arbeit und zeigten unter anderem an Pflanzen und Lebendexponaten, was Schaderreger wie Kartoffelkäfer, Fusarium, Mehlwürmer oder Pilzsporen anrichten können. In jeder Hinsicht war es lebendig am „Treffpunkt Pflanzenschutz und Pflanzenernährung“.